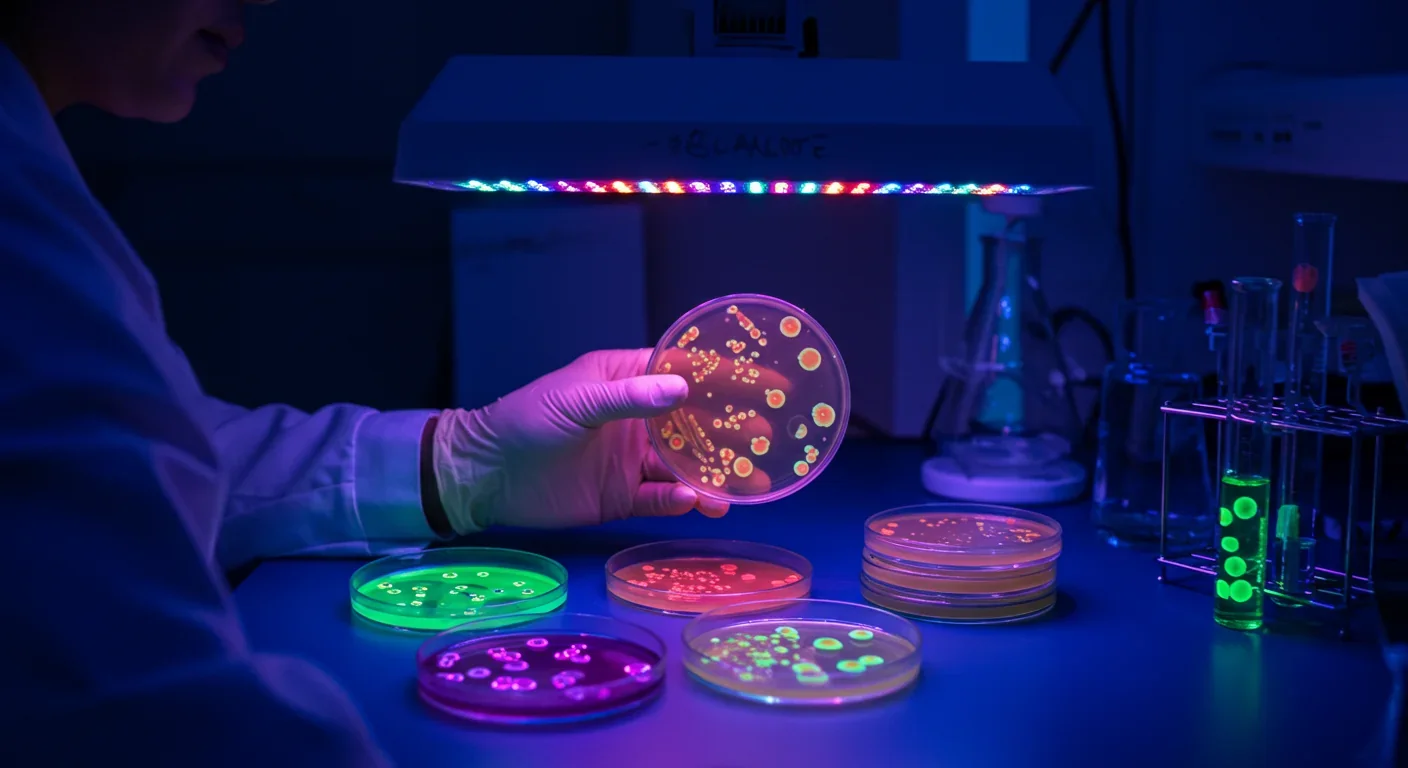

Bombardier Beetle Chemical Defense: Nature's Micro Engine

TL;DR: Extremophiles—organisms thriving in Earth's most hostile environments—are revolutionizing biotechnology, expanding our understanding of life's boundaries, and guiding the search for extraterrestrial life through their remarkable biochemical adaptations.

While most of us think boiling water or freezing ice defines the boundaries of life, there are organisms that laugh in the face of these limits. Meet the extremophiles—nature's daredevils that thrive where nothing else survives. They're rewriting biology textbooks, revolutionizing industries, and even guiding our search for aliens. The story of how life persists in Earth's harshest corners reveals something profound: the tenacity of biology knows almost no bounds.
Extremophiles aren't just tough—they're specialized. These organisms require extreme conditions to survive, making what would kill us feel like home. Scientists classify them based on their preferred environment: thermophiles love heat, psychrophiles prefer cold, acidophiles thrive in acid, halophiles flourish in salt, and piezophiles handle crushing pressure.
Consider Pyrolobus fumarii, an archaeon that holds the upper temperature limit for life at 113°C. It was discovered living on the walls of deep-sea hydrothermal vents, where superheated water meets frigid ocean depths. Even more extreme is Geogemma barossii (Strain 121), which can double its population at 121°C—the temperature of an autoclave used to sterilize medical equipment.
On the cold end, Antarctic bacteria produce enzymes that remain active near 0°C. The cold-adapted enzyme Est2 retains 20-85% activity between 0-15°C, perfect for breaking down organic matter in frozen environments. Meanwhile, Picrophilus species from acidic Japanese soils grow at pH 0—roughly the acidity of battery acid.
These aren't outliers. Extremophiles have been found in salt flats where water activity approaches zero, in radioactive waste pools, and miles beneath Earth's surface in solid rock. The message is clear: if liquid water exists, life finds a way.
How do extremophiles pull off these feats? The answer lies in their biochemical architecture. Every aspect of their cellular machinery has been fine-tuned for extreme conditions.
Protein Engineering by Evolution
Proteins are the workhorses of cells, but most denature—lose their shape and function—at temperatures above 60°C. Extremophile proteins have evolved hyperthermostability, maintaining structure and function where others would fall apart.
The secret involves multiple strategies. Hyperthermophilic proteins pack more tightly, with additional ionic bonds and hydrophobic interactions that resist thermal unraveling. They also have fewer flexible glycine residues in critical regions and more rigid proline residues that lock structures in place.
Psychrophiles take the opposite approach. Their proteins need flexibility at low temperatures, so they increase glycine content and reduce proline. The cold-adapted enzyme Est2 has an enlarged catalytic cavity (308.5 Ų versus 124.9 Ų for its mesophilic cousin) and more glycine residues near the active site, allowing substrate access even when molecular motion slows.
Membrane Remodeling
Cell membranes face their own challenges. In heat, typical lipid bilayers become too fluid and leak. In cold, they freeze solid. Extremophiles have evolved radically different membrane architectures.
Hyperthermophilic archaea use ether-linked tetraether lipids that span the entire membrane as a single monolayer, rather than the typical bilayer. This creates a more rigid, heat-resistant barrier. Some species adjust the number of cyclopentane rings in their lipids, fine-tuning membrane fluidity for different temperatures.
Psychrophiles go the other direction, incorporating more unsaturated fatty acids that remain fluid at low temperatures. It's like switching from butter to olive oil—one solidifies in the fridge, the other doesn't.
DNA Protection and Repair
DNA is particularly vulnerable to heat, which causes the double helix to denature. Hyperthermophiles counter this with reverse gyrase, an enzyme that introduces positive supercoils in DNA, making it more compact and stable. They also produce heat-shock proteins like Sac7d, which coat DNA and increase its melting temperature by up to 40°C.
Meanwhile, radiation-resistant bacteria like Deinococcus radiodurans survive doses of radiation that would be lethal to humans 3,000 times over. They do this through redundant DNA repair systems and multiple genome copies, allowing them to reconstruct damaged DNA like a biological jigsaw puzzle.
Specialized Metabolism
Energy metabolism also gets a makeover. Some hyperthermophiles use ADP-dependent kinases instead of conventional ATP-dependent enzymes for sugar metabolism. This adaptation appears unique to high-temperature organisms and may provide energy efficiency benefits at extreme heat.
Halophiles face a different challenge: maintaining osmotic balance in environments where salt concentrations exceed 30%. Some accumulate compatible solutes like glycerol or ectoine that stabilize proteins without disrupting their function. Others take a more radical approach, using a "salt-in" strategy where they maintain cytoplasmic salt concentrations matching the environment, requiring all their proteins to be adapted to work in brine.
The study of extremophiles isn't just academic curiosity—it's become a goldmine for biotechnology. Enzymes that work at extreme conditions are incredibly valuable for industrial processes.
The PCR Revolution
The most famous example is Taq polymerase from Thermus aquaticus, a bacterium discovered in Yellowstone's hot springs. Before Taq, the polymerase chain reaction (PCR)—used to amplify DNA—required adding fresh enzyme after every heating cycle because the enzyme would denature. Taq remains active at 95°C, allowing automated thermal cycling.
This breakthrough earned Kary Mullis a Nobel Prize in 1993 and transformed biology. PCR is now used for everything from diagnosing genetic diseases to identifying crime suspects from DNA traces to detecting viral infections. The COVID-19 pandemic made PCR testing a household term—all thanks to a microbe from a hot spring.
Cold-Active Enzymes
Psychrophilic enzymes are revolutionizing industries that operate at low temperatures. Cold-active proteases are used in laundry detergents that work in cold water, reducing energy consumption. They're also valuable for food processing, where heat would damage delicate flavors and nutrients.
The enzyme Est2 from Antarctic bacteria shows promise for bioremediation of cold environments, breaking down pollutants in places where conventional treatments fail.
Extremozymes in Manufacturing
Industrial chemical reactions often require high temperatures for speed or specific pH levels for selectivity. Using extremophile enzymes—"extremozymes"—allows these processes to run under extreme conditions without the enzyme degrading.
Halophilic bacteria produce biosurfactants that work in high-salt environments, useful for oil recovery and bioremediation of saline wastewater. Acid-loving organisms provide enzymes for biomining—extracting metals from low-grade ores using biological processes rather than harsh chemicals.
The pharmaceutical industry is particularly interested. Thermostable enzymes can catalyze reactions at high temperatures where substrates dissolve better and reactions proceed faster, increasing yields while reducing costs.
Many extremophiles don't go it alone—they form biofilms, structured communities encased in a protective matrix. These biological fortresses offer enhanced survival capabilities that individual cells can't achieve.
In biofilms, cells coordinate their behavior through chemical signaling. They can create microenvironments with different pH or oxygen levels, allowing specialized metabolism. The extracellular matrix shields cells from toxic chemicals, desiccation, and predation.
Researchers have found biofilms in some of Earth's most extreme locations: acidic mine drainage, Antarctic ice, deep-sea vents, and inside nuclear reactors. Understanding how biofilms enhance extremophile survival could lead to applications in industrial bioreactors, bioremediation, and materials science.
Some companies are already developing bioactive coatings using halophilic biofilms for corrosion resistance in marine environments. Others are studying biofilm architecture to design better water filtration systems or antimicrobial surfaces.
If life can survive in boiling acid on Earth, where else might it exist? This question drives much of astrobiology. Extremophiles have dramatically expanded our conception of habitable environments.
Mars once had liquid water, and may still have subsurface brines. The Martian surface is cold, dry, and bathed in radiation—conditions that would kill most Earth organisms but might suit radiation-resistant psychrophiles. Scientists are developing experiments to detect biosignatures that extremophiles might produce, using chemical lures to coax alien microbes out of hiding.
Europa, one of Jupiter's moons, has a subsurface ocean beneath kilometers of ice. The ocean floor may have hydrothermal vents similar to those on Earth where chemosynthetic extremophiles flourish. Enceladus, a moon of Saturn, sprays plumes of water into space that contain organic molecules and could harbor life.
Even more exotic environments look possible. Titan has lakes of liquid methane at -179°C. While no known organism could survive there, the discovery of extremophiles has taught us that life's chemistry is more flexible than we imagined. If metabolism can be rewired to work in boiling water or saturated brine, perhaps it could work in liquid methane too.
The study of extremophiles provides practical guidance for space missions. NASA's planetary protection protocols use extremophile research to determine sterilization requirements for spacecraft. We need to know what conditions truly sterilize to avoid contaminating other worlds with Earth life—or bringing extraterrestrial organisms back here.

The more we study extremophiles, the more we realize how arbitrary our assumptions about life have been. For decades, textbooks defined life's requirements based on organisms we knew: moderate temperatures, neutral pH, plenty of water and oxygen. Extremophiles have shredded those definitions.
There's now serious scientific debate about the upper temperature limit for life. The current record is 122°C for Methanopyrus kandleri, but is that the absolute ceiling? Above 122°C, certain biochemical bonds become unstable. Yet organisms keep surprising us. Each time we think we've found the limit, some microbe living somewhere we never thought to look extends it further.
The same applies to other extremes. We've found life at pH values from 0 to 12.5, in water as salty as saturated brine, under pressures exceeding 1,000 atmospheres, and in environments with radiation doses that would quickly kill humans. Ice-dwelling diatoms remain active at record-low temperatures, challenging assumptions about metabolism in frozen environments.
This expanding definition of habitability has profound implications. If life's boundaries are far wider than we thought, the universe may be teeming with organisms in places we'd dismissed as sterile.
Despite decades of research, we've barely scratched the surface of extremophile diversity. Most microorganisms can't be grown in laboratory cultures using standard techniques. Estimates suggest we've cultured less than 1% of microbial species.
New cultivation strategies are capturing previously uncultivated extremophiles. Techniques include using natural substrates, simulating natural conditions more precisely, and co-culturing organisms that depend on each other. Microfluidic devices can isolate and cultivate individual cells in tiny droplets, providing a more controlled environment.
Metagenomics—sequencing DNA directly from environmental samples—has revealed staggering diversity in extreme environments. Every hot spring, acid mine drainage, and deep-sea vent appears to host unique communities with novel metabolic capabilities. This untapped biodiversity represents a vast reservoir of potential biotechnological applications.
Companies are racing to characterize these organisms and patent useful enzymes before competitors do. It's a new kind of bioprospecting, with the harshest environments on Earth serving as treasure troves for the biotech industry.
Where does this field go next? Synthetic biology is one frontier. Researchers are trying to engineer extremophile traits into more tractable organisms. Imagine yeast or E. coli with thermostable proteins, acid-resistant membranes, or radiation-proof DNA repair systems. Such organisms could serve as platform hosts for industrial biotechnology under harsh conditions.
Climate change is making extremophile research more urgent. As temperatures rise and weather patterns shift, understanding organisms adapted to environmental extremes may help us predict and manage ecological changes. Some researchers are exploring whether extremophiles could be used for carbon capture in hot or saline environments where conventional approaches fail.
Space exploration will continue driving extremophile studies. As we plan missions to Mars, Europa, and beyond, we need to understand what life can withstand and what biosignatures it might produce. The organisms living in Earth's most extreme environments are our best models for what we might find elsewhere.
There's also medical potential. Extremophiles produce novel antimicrobial compounds, bioactive molecules, and polymers with unique properties. Radiation-resistant bacteria could help clean up nuclear contamination or protect astronauts from cosmic radiation. Heat-shock proteins from thermophiles are being investigated as treatments for protein-folding diseases.
Extremophiles teach us humility. Life is far more creative and adaptable than we give it credit for. The biochemical innovations these organisms have evolved over billions of years rival anything human engineers have devised.
They also teach us opportunity. Every harsh environment on Earth hosts life, and much of that life produces molecules and mechanisms we can harness. The extremophile in a hot spring today might provide the enzyme that transforms an industry tomorrow.
Most fundamentally, extremophiles remind us that life is resilient. It finds a way to persist in boiling water, frozen ice, concentrated acid, and saturated salt. It survives radiation that would sterilize most environments and pressure that would crush steel. Wherever liquid water exists, even briefly or in trace amounts, life seems to gain a foothold.
As we face environmental challenges and contemplate our future as a species, there's something reassuring about organisms that thrive in the most hostile places imaginable. If life can survive those extremes, perhaps it's tougher than we think—and perhaps there's hope for our own survival through whatever extremes lie ahead.
The extremophiles living on the fringes of habitability aren't just scientific curiosities. They're proof that life's fundamental drive to persist transcends the boundaries we once thought absolute. In understanding them, we understand something essential about the nature of life itself: given the slightest opportunity, it will not just survive but thrive.

Recent breakthroughs in fusion technology—including 351,000-gauss magnetic fields, AI-driven plasma diagnostics, and net energy gain at the National Ignition Facility—are transforming fusion propulsion from science fiction to engineering frontier. Scientists now have a realistic pathway to accelerate spacecraft to 10% of light speed, enabling a 43-year journey to Alpha Centauri. While challenges remain in miniaturization, neutron management, and sustained operation, the physics barriers have ...

Epigenetic clocks measure DNA methylation patterns to calculate biological age, which predicts disease risk up to 30 years before symptoms appear. Landmark studies show that accelerated epigenetic aging forecasts cardiovascular disease, diabetes, and neurodegeneration with remarkable accuracy. Lifestyle interventions—Mediterranean diet, structured exercise, quality sleep, stress management—can measurably reverse biological aging, reducing epigenetic age by 1-2 years within months. Commercial ...

Data centers consumed 415 terawatt-hours of electricity in 2024 and will nearly double that by 2030, driven by AI's insatiable energy appetite. Despite tech giants' renewable pledges, actual emissions are up to 662% higher than reported due to accounting loopholes. A digital pollution tax—similar to Europe's carbon border tariff—could finally force the industry to invest in efficiency technologies like liquid cooling, waste heat recovery, and time-matched renewable power, transforming volunta...

Humans are hardwired to see invisible agents—gods, ghosts, conspiracies—thanks to the Hyperactive Agency Detection Device (HADD), an evolutionary survival mechanism that favored false alarms over fatal misses. This cognitive bias, rooted in brain regions like the temporoparietal junction and medial prefrontal cortex, generates religious beliefs, animistic worldviews, and conspiracy theories across all cultures. Understanding HADD doesn't eliminate belief, but it helps us recognize when our pa...

The bombardier beetle has perfected a chemical defense system that human engineers are still trying to replicate: a two-chamber micro-combustion engine that mixes hydroquinone and hydrogen peroxide to create explosive 100°C sprays at up to 500 pulses per second, aimed with 270-degree precision. This tiny insect's biochemical marvel is inspiring revolutionary technologies in aerospace propulsion, pharmaceutical delivery, and fire suppression. By 2030, beetle-inspired systems could position sat...

The U.S. faces a catastrophic care worker shortage driven by poverty-level wages, overwhelming burnout, and systemic undervaluation. With 99% of nursing homes hiring and 9.7 million openings projected by 2034, the crisis threatens patient safety, family stability, and economic productivity. Evidence-based solutions—wage reforms, streamlined training, technology integration, and policy enforcement—exist and work, but require sustained political will and cultural recognition that caregiving is ...

Every major AI model was trained on copyrighted text scraped without permission, triggering billion-dollar lawsuits and forcing a reckoning between innovation and creator rights. The future depends on finding balance between transformative AI development and fair compensation for the people whose work fuels it.